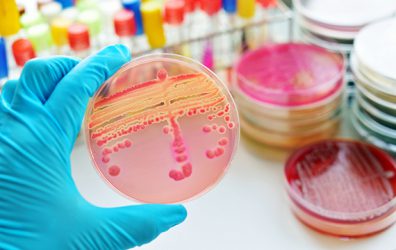

La competencia general de este Título consiste en realizar estudios analíticos de muestras biológicas, siguiendo los protocolos normalizados de trabajo, aplicando las normas de calidad, seguridad y medioambientales establecidas, y valorando los resultados técnicos, para que sirvan como soporte a la prevención, al diagnóstico, al control de la evolución y al tratamiento de la enfermedad, así como a la investigación, siguiendo los protocolos establecidos en la unidad asistencial.
Las personas que obtienen este Título ejercen su actividad en el sector sanitario, en organismos e instituciones del ámbito público y en empresas privadas, en el área del laboratorio de análisis clínicos y en el diagnóstico, tratamiento, gestión e investigación.
Actúan como trabajadoras y trabajadores dependientes, pudiendo ser el organismo o institución pequeño, mediano o grande.